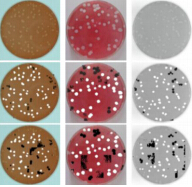
Detection and segmentation of virus plaque using HOG and SVM: Toward automatic plaque assay

论文投稿前,文章的第一作者需要填写《科研论文投稿知情同意表》,论文的所有作者必须签名,并且,实验负责老师也需要签名确认。表格下载见附件1。
审稿期间有修改或后期改投期刊等,都需要在原先的《科研论文投稿知情同意表》后附上论文的修改说明并签字,如果修改内容较多可以打印签字后粘贴在表格后。
论文录用后,文章的第一作者需要填写《科研论文录用知情同意表》,论文的所有作者必须签名,并且,实验负责老师也需要签名确认。表格下载见附件2。
论文投稿前务必要确认实验室标注信息无误。备注信息如下:
2026年足球世界杯直播基础医学院数字医学研究中心
Digital Medical Research Center, School of Basic Medical Sciences, Fudan University
上海市医学图像处理与计算机辅助手术重点实验室
Shanghai Key Laboratory of Medical Imaging Computing and Computer Assisted Intervention
附件1:2026年足球世界杯直播数字医学研究中心科研论文投稿知情同意表.docx
附件2:2026年足球世界杯直播数字医学研究中心科研论文录用知情同意表.docx


Qiuye Jin, Mingzhi Yuan, Qin Qiao, Zhijian Song
下载链接:https://github.com/fdujay/One-shot-AL

Yinlong Liu, Yuan Dong, Zhijian Song, Manning Wang
下载链接:https://github.com/fdyuandong/2D-3D-Point-Set-Registration-Based-on-Global-Rotation-Search
Yihao Mao, Hong Liu, Rong Ye, Yonghong Shi, and Zhijian Song
文章及代码链接: https://pan.baidu.com/s/1CG3qE_Nfe-JlsOQlNbLWfQ 提取码: pxk3

下载链接: http://pan.baidu.com/s/1qY4C9Y0 密码: 65ex